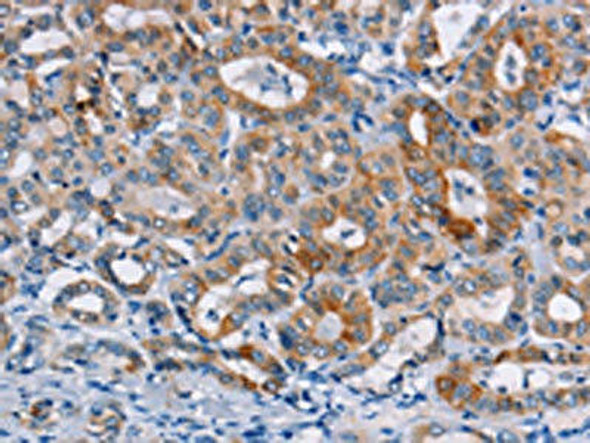
CASC3 Antibody (PACO15934)

Antibodies
- Product
- Qty in Cart
- Quantity
- Price
- Subtotal
-

CCDC106 Antibody (PACO15942)
// system_update_altDatasheetsystem_update_altMSDSOverviewAntibody Name:CCDC106 Antibody (PACO15942)Antibody SKU:PACO15942Size:50ulHost Species:RabbitTested Applications:ELISA, IHCRecommended Dilutions:ELISA:1:2000-1:10000, IHC:1:100-1:300Species...Qty in Cart: 0Price:Subtotal: -

CATSPER3 Antibody (PACO15941)
// system_update_altDatasheetsystem_update_altMSDSOverviewAntibody Name:CATSPER3 Antibody (PACO15941)Antibody SKU:PACO15941Size:50ulHost Species:RabbitTested Applications:ELISA, WBRecommended Dilutions:ELISA:1:2000-1:5000, WB:1:500-1:2000Species...Qty in Cart: 0Price:Subtotal: -

CATSPER3 Antibody (PACO15940)
// system_update_altDatasheetsystem_update_altMSDSOverviewAntibody Name:CATSPER3 Antibody (PACO15940)Antibody SKU:PACO15940Size:50ulHost Species:RabbitTested Applications:ELISA, IHCRecommended Dilutions:ELISA:1:2000-1:10000, IHC:1:100-1:300Species...Qty in Cart: 0Price:Subtotal: -

CATSPER4 Antibody (PACO15939)
// system_update_altDatasheetsystem_update_altMSDSOverviewAntibody Name:CATSPER4 Antibody (PACO15939)Antibody SKU:PACO15939Size:50ulHost Species:RabbitTested Applications:ELISA, IHCRecommended Dilutions:ELISA:1:1000-1:5000, IHC:1:50-1:200Species...Qty in Cart: 0Price:Subtotal: -

CASC3 Antibody (PACO15935)
// system_update_altDatasheetsystem_update_altMSDSOverviewAntibody Name:CASC3 Antibody (PACO15935)Antibody SKU:PACO15935Size:50ulHost Species:RabbitTested Applications:ELISA, IHCRecommended Dilutions:ELISA:1:1000-1:2000, IHC:1:25-1:100Species...Qty in Cart: 0Price:Subtotal: -
CASC3 Antibody (PACO15934)
// system_update_altDatasheetsystem_update_altMSDSOverviewAntibody Name:CASC3 Antibody (PACO15934)Antibody SKU:PACO15934Size:50ulHost Species:RabbitTested Applications:ELISA, WB, IHCRecommended Dilutions:ELISA:1:1000-1:2000, WB:1:200-1:1000,...Qty in Cart: 0Price:Subtotal: -

CAPZA3 Antibody (PACO15925)
// system_update_altDatasheetsystem_update_altMSDSOverviewAntibody Name:CAPZA3 Antibody (PACO15925)Antibody SKU:PACO15925Size:50ulHost Species:RabbitTested Applications:ELISA, IHCRecommended Dilutions:ELISA:1:2000-1:5000, IHC:1:50-1:200Species...Qty in Cart: 0Price:Subtotal: -

CAPZA3 Antibody (PACO15924)
// system_update_altDatasheetsystem_update_altMSDSOverviewAntibody Name:CAPZA3 Antibody (PACO15924)Antibody SKU:PACO15924Size:50ulHost Species:RabbitTested Applications:ELISA, IHCRecommended Dilutions:ELISA:1:2000-1:5000, IHC:1:50-1:200Species...Qty in Cart: 0Price:Subtotal: -

NCAPD3 Antibody (PACO15921)
// system_update_altDatasheetsystem_update_altMSDSOverviewAntibody Name:NCAPD3 Antibody (PACO15921)Antibody SKU:PACO15921Size:50ulHost Species:RabbitTested Applications:ELISA, IHCRecommended Dilutions:ELISA:1:2000-1:5000, IHC:1:50-1:200Species...Qty in Cart: 0Price:Subtotal: -

BTN2A2 Antibody (PACO15893)
// system_update_altDatasheetsystem_update_altMSDSOverviewAntibody Name:BTN2A2 Antibody (PACO15893)Antibody SKU:PACO15893Size:50ulHost Species:RabbitTested Applications:ELISA, IHCRecommended Dilutions:ELISA:1:2000-1:5000, IHC:1:25-1:100Species...Qty in Cart: 0Price:Subtotal: -

BTN2A2 Antibody (PACO15892)
// system_update_altDatasheetsystem_update_altMSDSOverviewAntibody Name:BTN2A2 Antibody (PACO15892)Antibody SKU:PACO15892Size:50ulHost Species:RabbitTested Applications:ELISA, IHCRecommended Dilutions:ELISA:1:2000-1:5000, IHC:1:25-1:100Species...Qty in Cart: 0Price:Subtotal: -

SLAMF8 Antibody (PACO15873)
// system_update_altDatasheetsystem_update_altMSDSOverviewAntibody Name:SLAMF8 Antibody (PACO15873)Antibody SKU:PACO15873Size:50ulHost Species:RabbitTested Applications:ELISA, IHCRecommended Dilutions:ELISA:1:1000-1:5000, IHC:1:50-1:200Species...Qty in Cart: 0Price:Subtotal:
